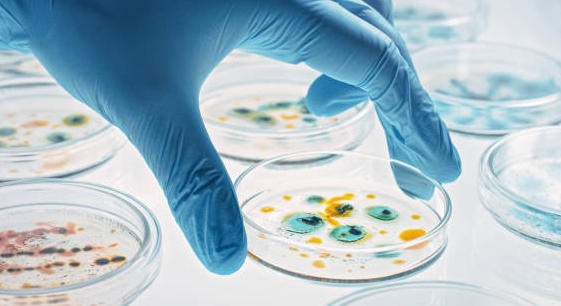
Une seule santé : ou comment sauver l&rsquo;avenir de l’humanité

- Accueil ›
- Profession ›
- Socioprofessionnel ›
- Une seule santé : ou comment sauver l’avenir de l’humanité
© Getty Images/iStockphoto
Une seule santé : ou comment sauver l’avenir de l’humanité
« Une seule santé humaine, animale et environnementale : l’équation de notre avenir » est un bon résumé du concept « One Health » (« une seule santé », en français) qui s’est développé aux débuts des années 2000 et qui est mis en avant depuis la pandémie de Covid-19. C’était aussi le thème du colloque qui s’est tenu à Bordeaux (Gironde) le jeudi 31 mars, organisé par le magazine L’Obs et le groupe 1Health (1).
« L’origine du Covid-19 est probablement une zoonose due à l’introduction d’un coronavirus à partir d’un réservoir animal », a conclu le conseil scientifique français. L’apparition Sars-Cov-2 a donc mis en exergue le lien entre le monde humain et le monde animal avec le franchissement de la barrière d’espèce, mais également le rôle qu’auraient pu jouer les vétérinaires dans la gestion de cette crise sanitaire. Ainsi que la nécessité de prévenir les futures épidémies en ayant une vision globale de la santé des espèces vivantes et végétales.
Le nombre d’épidémies en forte augmentation
« Depuis les années 60, nous assistons à une augmentation du nombre d’épidémies de maladies zoonotiques, une augmentation des maladies vectorielles, des maladies affectant les animaux d’élevages et de celles qui concernent la faune sauvage, et également des maladies, notamment fongiques, affectant la végétation sur l’ensemble de la planète », déclare Serge Morand, écologue du Cirad (Centre de coopération internationale en recherche agronomique pour le développement). Plusieurs phénomènes expliquent cette situation. Le changement climatique, mais aussi l’empreinte croissante de l’élevage sur notre environnement : entre 1960 et 2020, nous sommes passés au niveau mondial de moins d’un milliard de têtes de bétail à plus d’1,6 milliard, de 500 millions de porcs à 1,5 milliard et de 4 milliards de poulets à 40 milliards. « Le poids de la biomasse des vaches sur la planète est plus important que celui de la biomasse des humains », commente-t-il. Pire encore, selon l’écologue, « le nombre de poulets va bientôt dépasser celui des oiseaux sauvages qui, lui, est passé de 300 milliards en 1997 à 50 milliards aujourd’hui ». L’extension et l’intensification de l’agriculture jouent également un rôle important dans les pertes de biodiversité avec une hausse de 9 % des terres agricoles depuis 2003, ainsi que la déforestation et la croissance des surfaces de plantations commerciales. Enfin, les échanges commerciaux et le tourisme contribuent à la circulation des maladies.
Agir et anticiper
Pour Serge Morand, la prévention des épidémies est essentielle et doit intégrer de nouvelles approches territoriales. De nombreuses actions sont déjà engagées en France. Par exemple, le Conseil régional de Nouvelle Aquitaine va élaborer une feuille de route sur la santé, en organisant des concertations en association avec des médecins, des vétérinaires et plus largement des professionnels de santé notamment sur l’accès aux soins tant pour les résidents que pour les éleveurs. Un véritable enjeu sachant que la région fait face à une troisième épidémie de grippe aviaire en quatre ans, qui a conduit à l’abattage de 14 000 volailles. Le Conseil régional a aussi lancé il y a cinq ans le projet « Vitirêve » afin d’aider les viticulteurs à ne plus utiliser de pesticides d’ici 2030. L’université de Limoges (Haute-Vienne) a également créé un master One Health ouvert aux professionnels de santé et aux vétérinaires. Autre exemple d’action internationale : le projet Prezode (Preventing ZOonotic Disease Emergence) lancé en 2021, qui vise à comprendre les risques d’émergence de maladies infectieuses zoonotiques, à améliorer la prévention et la détection précoce, et assurer une réponse rapide face à une épidémie. L’Institut de recherche pour le développement (IRD) est ainsi présent au Yucatan (Mexique) pour participer à cette initiative qui regroupe aujourd’hui 130 partenaires et 10 pays dont la France.
(1)L’Obs et 1 Health avec le soutien de Ceva, MSD Santé animale, Viatris et la région Nouvelle-Aquitaine.
- Rémunération des pharmaciens : une réforme majeure se prépare-t-elle ?
- Les métiers de l’officine enfin reconnus à risques ergonomiques
- Remises génériques : l’arrêté rectificatif en passe d’être publié
- Réforme de la rémunération officinale : quelles sont les propositions sur la table ?
- Paracétamol : quel est cet appel d’offres qui entraînera des baisses de prix ?
- Comptoir officinal : optimiser l’espace sans sacrifier la relation patient
- Reishi, shiitaké, maitaké : la poussée des champignons médicinaux
- Budget de la sécu 2026 : quelles mesures concernent les pharmaciens ?
- Cancers féminins : des voies de traitements prometteuses
- Vitamine A Blache 15 000 UI/g : un remplaçant pour Vitamine A Dulcis




